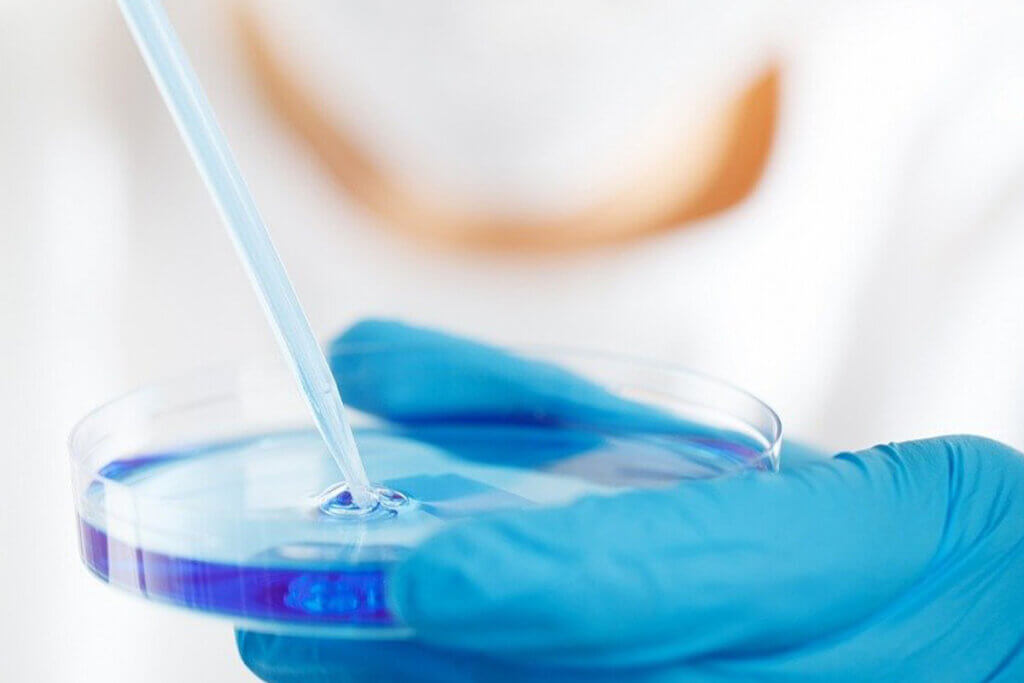

In Österreich werden jedes Jahr Hunderttausende Tiere in grausamen und unwissenschaftlichen Tierversuchen gequält. [1] In Österreich gibt es 400 Versuchslabore, [2] in denen jeden Tag Tiere misshandelt werden – obwohl es bereits zahlreiche Alternativen gibt.
Über 200.000 Tiere jährlich in Tierversuchen missbraucht
Jedes Jahr werden über 200.000 Kaninchen, Mäuse, Ratten und andere Tiere in österreichischen Versuchslaboren für wissenschaftliche Zwecke missbraucht. 2020 waren es 206.469 Individuen. [1] Lediglich Versuche an Menschenaffen wie Gorillas oder Schimpansen sind seit 2006 in Österreich verboten. [3]
In der gesamten EU werden jährlich etwa 10 Millionen Tiere gequält und getötet. [4] Dabei werden die fühlenden Individuen vergiftet, verbrannt, mit Krankheiten infiziert, zwangsernährt und verätzt. Zählt man die Tiere mit, die für die Zucht missbraucht oder einfach wie „Überschussware“ weggeworfen werden, handelt es sich sogar um 22 Millionen Tiere. [5] Zwar lautet das Ziel der EU-Tierversuchsrichtlinie, Tierversuche „für wissenschaftliche Zwecke und Bildungszwecke vollständig zu ersetzen“, [6] dennoch erreichte die Anzahl der in Österreich misshandelten Tiere im Jahr 2018 ein trauriges Rekordhoch. [7]

Tierversuche sind ungenau und sinnlos
Es hat sich bereits oft gezeigt, dass die Ergebnisse aus Tierversuchen nicht gut auf den Menschen übertragen werden können. In zahlreichen Forschungsbereichen gibt es erhebliche Mängel: Beispielsweise kommen etwa 97 Prozent aller neuen potenziellen Medikamente für die Behandlung von Krebs nicht auf den Markt, obwohl sie zuvor in Tierversuchen für sicher und wirksam befunden wurden – in der Alzheimerforschung liegt die Misserfolgsquote sogar bei 99,6 Prozent. [8, 9]
Stärkere Finanzierung von tierfreien Alternativen geplant
Im Juli 2020 hatte der österreichische Bundesrat entschieden, tierversuchsfreie Forschung stärker zu fördern. Innovativen Testmethoden sollte derselbe Geldbetrag zur Verfügung gestellt werden wie Versuchen an Tieren. [10] Damit hätte Österreich sich einen enormen Vorsprung in der Forschung verschafft.
Leider hat der Nationalrat dem Vorhaben (noch) nicht zugestimmt und es ist auch nicht anzunehmen, dass er dies zeitnah thematisieren wird, da der Rat erst 2020 die Förderung von tierfreien Methoden auf 600.000 Euro verdoppelt hat. [11] Zwar ist diese Erhöhung besser als nichts, aber gleichzeitig auch nur ein Bruchteil dessen, was in Tierversuche fließt. Die Entscheidung des Rates wäre ein erster Schritt in Richtung des letztendlichen Ziels der EU gewesen, Tierversuche komplett abzuschaffen. [6] Dass Österreich eine Rolle als wissenschaftlicher Wegbereiter einnimmt, wird also auf unbestimmte Zeit verschoben.
PETAs Strategiepapier zum Ausstieg aus Tierversuchen
Mit dem Research Modernisation Deal – einem Strategiepapier zur Modernisierung der Forschung und zum Ausstieg aus Tierversuchen – legen wir von PETA ein Konzept vor, das bei der Förderung von tierfreien Forschungsmethoden unterstützen kann. Wir hoffen sehr, dass der Nationalrat doch noch für die Tiere entscheidet und das Ende der grausamen Tierversuche einleitet.
Fordern auch Sie das Ende der Tierversuche!
Immer mehr Politiker:innen, Behörden und Wissenschaftler:innen erkennen das Potenzial tierfreier Forschungsmethoden. Helfen Sie uns, diese Entwicklung schneller voranzubringen, und fordern Sie die Entscheidungsträger:innen auf nationaler und europäischer Ebene auf, unsere Forschung zu modernisieren!
-
Quellen
[1] Bundesministerium für Bildung, Wissenschaft und Forschung: Tierversuchsstatistik (2020), https://www.bmbwf.gv.at/dam/jcr:5be7eb7b-9600-4e46-98fe-39fc56570b5a/Tierversuchsstatistik_2020.pdf (eingesehen am 11.07.2022)
[2] Österreichischer Tierschutzverein (24.01.2019): Grausam, unethisch, vermeidbar: Tierversuche in Österreich, https://tierschutzverein.at/tierversuche-in-oesterreich/ (eingesehen am 11.07.2022)
[3] Veterinärmedizinische Universität Wien: Was Sie über Tierversuche wissen sollten, https://www.vetmeduni.ac.at/fileadmin/v/forschung/dokumente/infobroschuere_tierversuche.pdf (eingesehen am 11.07.2022)
[4] European Commission (2022): 2019 Statistical Report, SWD(2022)199: Executive summary Parts A and B and Part C, https://ec.europa.eu/environment/chemicals/lab_animals/pdf/SWD2019_Part_A_and_B.pdf, https://ec.europa.eu/environment/chemicals/lab_animals/pdf/SWD2019_Part_C.pdf (eingesehen am 19.07.2022)
[5] Europäische Kommission (2019): Bericht der Kommission an das Europäische Parlament und den Rat, Bericht 2019 über die statistischen Daten über die Verwendung von Tieren für wissenschaftliche Zwecke in den Mitgliedstaaten der Europäischen Union in den Jahren 2015-2017, https://eur-lex.europa.eu/legal-content/DE/TXT/PDF/?uri=COM:2020:16:FIN&qid=1580912477343&from=DE (eingesehen am 11.07.2022)
[6] Richtlinie 2010/63/EU des Europäischen Parlaments und des Rates vom 22. September 2010 zum Schutz der für wissenschaftliche Zwecke verwendeten Tiere. https://eur-lex.europa.eu/legal-content/DE/TXT/PDF/?uri=CELEX:32010L0063&from=EN (eingesehen am 24.11.2020)
[7] Statista: (16.11.2021): Anzahl der Tierversuche in Österreich von 2010 bis 2020, https://de.statista.com/statistik/daten/studie/880957/umfrage/tierversuche-in-oesterreich/ (eingesehen am 03.08.2022)
[8] Wong CH, Siah KW, Lo AW. Estimation of clinical trial success rates and related parameters. Biostatistics. 2018;kxx069
[9] Pistollato F, Ohayon EL, Lam A, et al. Alzheimer disease research in the 21st century: Past and current failures, new perspectives and funding opportunities. Oncotarget. 2016;7(26):38999-39016
[10] Parlament Republik Österreich: Entschließung des Bundesrates vom 16. Juli 2020 betreffend Förderung tierversuchsfreier Forschung sowie Berichtslegung an den Bundesrat, https://www.parlament.gv.at/PAKT/VHG/BR/E-BR/E-BR_00320/fnameorig_812623.html (eingesehen am 11.07.2022)
[11] Der Standard (21.07.2020): Zahl der Tierversuche in Österreich gestiegen, https://www.derstandard.de/story/2000118884345/zahl-der-tierversuche-in-oesterreich-gestiegen (eingesehen am 11.07.2022)
